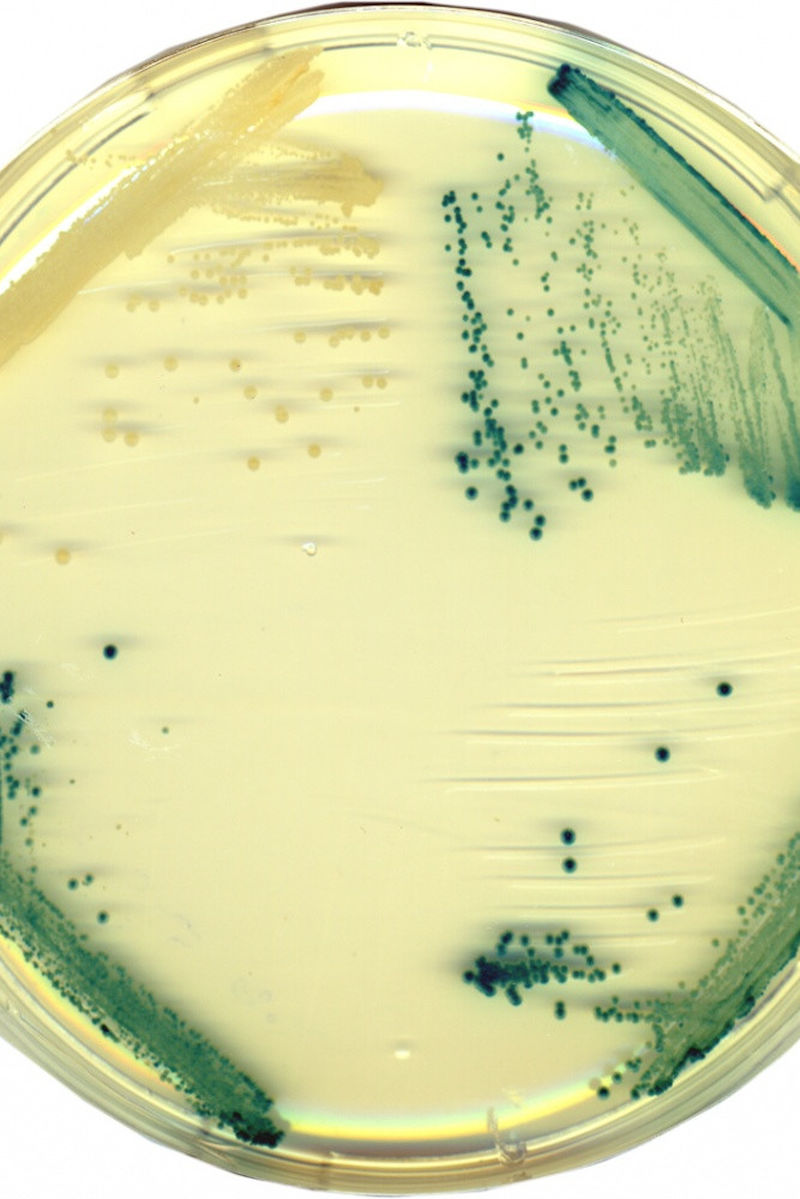

Ein Hefepilz als Hühnerpille

Seit zweieinhalb Jahren arbeiten die Hefegenetikerin und der Virologe in ihrem Projekt „Vakzinova“ an einer „Hefepille“, die zum Beispiel Hühner gegen hochansteckende Krankheiten immunisieren soll. Mit ihrer ersten Zusammenarbeit begeben sich die Biologen auf ein weitgehend unerforschtes Gebiet. Weltweit arbeiten zurzeit mehrere Forschergruppen an der Entwicklung oraler Impfstoffe für Tiere, aber das MLU-Konzept ist völlig neu. „Wir sparen uns einen riesigen Aufwand bei der Impfstoff-Produktion, indem wir ganze Hefen verfüttern“, sagt Professor Behrens.
„Wir arbeiten mit dem Haustier von Frau Breunig – einer Milchhefe, die mit der Bäckerhefe vergleichbar ist“, erzählt er. Kluyveromyces lactis, mit dem Karin Breunig schon seit über 25 Jahren arbeitet, war offenbar die richtige Wahl. Sie löst tatsächlich nach der Verfütterung im Körper der Tiere eine spezifische Immunantwort aus. „Die Hefe stimuliert das Immunsystem der Tiere nicht nur allgemein, sondern so, dass im Blut Antikörper die gewünschten Antikörper produziert werden können“, erläutert Professorin Breunig.
Damit die Tiere nach einer solchen Impfung wirksam gegen Infektionen geschützt sind, müssen ganz unterschiedliche Probleme gelöst werden: „Wir haben zunächst verschiedene Virusantigene getestet, die gegen bestimmte Krankheiten immunisieren können“, erklärt der Virologe Behrens, „denn im Unterschied zu gängigen Impfverfahren immunisieren wir nicht mit dem Virus selbst, sondern lediglich mit Strukturen seiner Oberfläche“.
Der Impfstoff wird nicht wie sonst üblich als Virus in Tieren herangezüchtet, sondern besteht aus genetisch modifizierten Hefen. „Das ist nicht nur kostengünstiger sondern auch viel tierfreundlicher“, erläutert Behrens. Dazu arbeitete Karin Breunig an verschiedenen Hefestämmen. „Die Hefe muss genetisch so verändert werden, dass sie die antigenen Virusproteine in großer Menge selbst herstellt“, sagt sie. Einer der entwickelten Stämme wurde an Hühnern erfolgreich getestet und lieferte damit den „proof of principle“.
Ein Zehntel der geimpften Tiere war gegen eine Geflügelkrankheit Infektiöse Bursitis geschützt. „Diesen Prototyp wollen wir jetzt so optimieren, dass das Verfahren industriell anwendbar wird“, sagt Sven-Erik Behrens. In etwa zweieinhalb Jahren soll der Impfstoff marktreif sein. Den erfolgreichen Hefestamm und das Impfverfahren haben sich die beiden Wissenschaftler schon patentieren lassen.